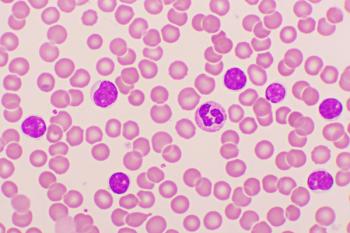

Hematology
Latest News
Latest Videos

CME Content
More News

Undetectable minimal residual disease rates improved with ongoing therapy.

Iman Ahmed, PharmD, BCOP, shared key insights about how social determinants of health impact treatment access and outcomes for patients with leukemia.

Zahra Mahmoudjafari, PharmD, BCOP, FHOPA, shared insight from the HOPA Annual Meeting 2025.

Arefa Bacchus, PharmD, shared key insights about the use of POMP therapy in patients with acute lymphoblastic leukemia (ALL).

Current treatment strategies are aimed at reducing hematocrit and symptom burden through phlebotomy, aspirin, and cytoreductive agents, while emerging therapies offer promise for better disease control and quality of life.

Mark Zangardi, PharmD, MS, BCOP, and Amber Cipriani, PharmD, BCOP, discuss the growing role of circulating tumor DNA (ctDNA) testing in oncology, highlighting its applications in early cancer detection, molecular residual disease assessment, and treatment monitoring.

Amir Ali, PharmD, BCOP, and Allison Hsieh, PharmD share insights from their presentation about cytokine release syndrome, ICANS, and CAR T-cell therapy.

Matthew Lei, PharmD, BCOP, highlights the value of community, collaboration, and innovation at the HOPA Annual Conference.

The multiple myeloma landscape is evolving, with bispecific T-cell engagers offering hope.

The trial showed that adding pelabresib to ruxolitinib improved outcomes in myelofibrosis with manageable adverse effects.

CAV-1 is a key protein in lipid rafts that helps control cellular processes such as growth, survival, and migration.

Siremadlin is a novel, investigational, second-generation antagonist that binds to MDM2.

Real-time profiling of T-cell activation states in non-CAR T-cells may help guide treatment decisions.
Pharmacists performed weekly toxicity and tumor lysis syndrome monitoring.

Patients with chronic lymphocytic leukemia (CLL) show weakened T-cell memory responses to COVID-19 vaccination.

Using Janus kinase inhibitors, having experienced a previous thrombosis episode, and higher age were associated with a heightened risk of a new thromboembolic event.

Adding daratumumab improved minimal residual disease (MRD) negativity rates, leading to superior progression-free survival (PFS).

Patients with central nervous system (CNS) involvement achieved favorable outcomes with chimeric antigen receptor (CAR) T-cell therapy.

Reducing the dose of ibrutinib following adverse events improved tolerability without compromising clinical efficacy in chronic lymphocytic leukemia (CLL).

A phase 2 study showed that elotuzumab combined with pomalidomide, bortezomib, and dexamethasone was safe and efficacious.

David S. Bateshansky, PharmD, BCOP, discusses his role as an oncology pharmacist at USC Norris Comprehensive Cancer Center, noting the evolving recognition of pharmacists' contributions on cancer care teams.

Lipid metabolism plays a critical role in the function of T-cells.

Approximately 10% of patients with multiple myeloma have pathogenic germline variants, indicating a hereditary risk.

Use of dexamethasone over tocilizumab was associated with significant cost-savings for patients with relapsed/refractory multiple myeloma (RRMM).

The favorable outcomes were observed in the phase 3 AMPLIFY trial.



























































































































































































































